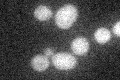
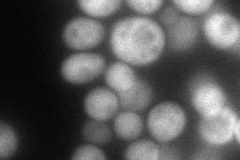
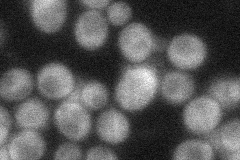
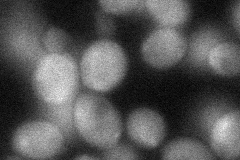
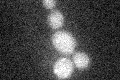

View description
Subunit of Elongator complex, which is required for modification of wobble nucleosides in tRNA; required for Elongator structural integrity
Localization:
Intensity:
Fold change:
Significance:
-
C’ GFP library in SD
below threshold18.86 -
N' NOP1pr-GFP in SD

cytosol107.927 -
N' TEF2pr-mCherry in SD
cytosol86.4807 -
N' NATIVEpr-GFP in SD
cytosol39.006 -
N' TEF2pr-VC and Cyto-VN in SD
cytosol40.1027 -
C’ GFP library in SD+DTT

cytosol18.280.96No -
C’ GFP library in SD+H2O2
cytosol17.250.91No -
C’ GFP library in Starvation Media

cytosol15.520.82No -
C’ GFP library on the background of Pup2-DaMP

below threshold -
C’ GFP library on the background of CCT mutant

below threshold23.80621.26182No
